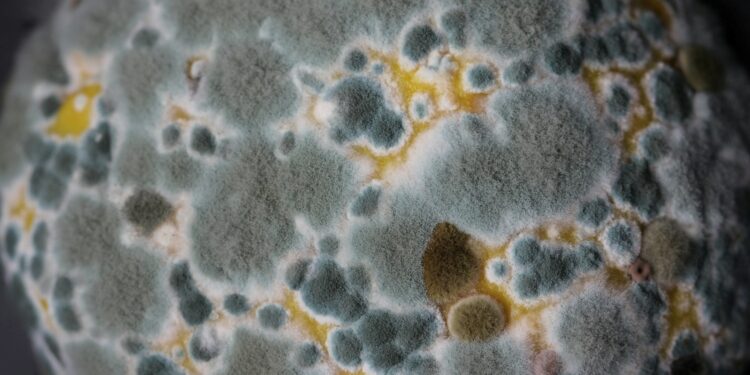
Marca gigante vai pagar R$ 14,99 de indenização por comida mofada

Uma indenização recente chamou a atenção dos consumidores. Geralmente, alimentos vencidos ou com mofo figuram entre as maiores preocupações das empresas do ramo alimentício, considerando que, por representarem riscos de saúde aos clientes, podem acabar desencadeando grandes disputas judiciais.
Apesar disso, nem todas as decisões resultam em altos valores de indenização. Inclusive, em um exemplo recente, o supermercado Assaí e a empresa de alimentos Seara foram condenados ao pagamento de uma indenização simbólica de apenas R$ 14,99, conforme relatado pelo site Migalhas.
O caso foi julgado pela 1ª vara Cível de Limeira, São Paulo, e de acordo com os autos, a autora do processo constatou que um produto da marca adquirido no estabelecimento acabou apresentando bolor mesmo ainda estando no prazo de validade.
Apesar da alegação das empresas de que o produto teria sido armazenado de forma inadequada pela consumidora, o magistrado entendeu que houve falha comprovada na cadeia de fornecimento, e com isso descartou a possibilidade de culpa exclusiva da cliente.
Todavia, mesmo com a vitória da autora, uma vez que ficou reconhecida a responsabilidade das rés, o juiz responsável pelo caso definiu que o reembolso do valor pago, acrescido de juros legais, seria suficiente para resolver a situação.
Indenização barata: por que valor fixado por tribunal foi tão baixo?
Ainda de acordo com os autos do processo, a autora chegou a solicitar indenização por danos morais. No entanto, o magistrado entendeu que o caso não configurou violação à dignidade da consumidora a ponto de justificar o pagamento da compensação.
Isso porque não houve prova de que o produto foi consumido ou apresentou algum risco concreto à saúde. Desta forma, baseando-se nos precedentes do Tribunal de Justiça de São Paulo, o juiz determinou que a situação não passou de um mero aborrecimento.
Vale destacar ainda que, por pouco, a consumidora não precisou arcar com custas mais altas que o valor da indenização. Afinal, o juiz reconheceu sucumbência recíproca, e com isso determinou que cada parte arque com metade das custas e dos honorários, fixados em R$ 500, respeitada a gratuidade judicial da autora.